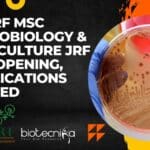
MSSRF MSc Microbiology & Agriculture JRF Job Opening, Applications Invited MSSRF MSc Microbiology

Home Search
biology - search results
If you're not happy with the results, please do another search
MSc Biology Candidates Apply For Project Associate Job at IISER Tirupati
IISER Tirupati Biology Associate Opening - Project Associate Vacancy
IISER Tirupati Biology Associate Opening - Project Associate Vacancy. MSc Biology Job. Project jobs at IISER...
CCRAS-CARI Biotechnology & Microbiology Research Jobs, Attend Walk-In
CARI Research Jobs 2022 For Biotech, Microbiology - Walk-In
CARI Research Jobs 2022 For Biotech, Microbiology - Walk-In. MSc Biotechnology, Microbiology JRF job openings at...
Unilever MSc & BTech Biotech, Biochem, Biology, Plant Science Research Executive
Unilever Research Executive Job For MSc & BTech, Apply Online
Unilever Research Executive Job For MSc & BTech, Apply Online. BS Biology Job. MSc Agriculture...
UPSC Scientific Officer Job For MSc Microbiology, Biotech, Biochem, Zoology, Botany, Genetics
UPSC Job Opening 2022 For Biochem, Forensic Science, Biotech & More
UPSC Job Opening 2022 For Biochem, Forensic Science, Biotech & More. UPSC Recruitment Latest....
MACS ARI Pune BSc Biotech & Microbiology Project Assistant Job Opening
ARI Pune BSc Job For Biotech & Microbiology, Applications Invited
ARI Pune BSc Job For Biotech & Microbiology, Applications Invited. BSc Microbiology and Biotechnology Project...
CSIR-URDIP Project Job For MSc, BTech Microbiology, Botany, Biotech, Biochem – Apply Online
CSIR-URDIP Project Job For MSc & BTech, Apply Online
CSIR-URDIP Project Job For MSc & BTech, Apply Online. MSc, BTech Microbiology, Botany, Biotech, Biochem job...
ICMR-National Institute of Virology Biotech, Microbiology, Life Sciences Job
NIV Pune Project SRF Job - Life Sciences Project Vacancy
NIV Pune Project SRF Job - Life Sciences Project Vacancy. National Institute of Virology Jobs....
CFTRI Microbiology, Biotech, Biochem Research Fellow Job, Apply Online
CFTRI JRF Job 2022 For MSc Candidates - Apply Online
CFTRI JRF Job 2022 For MSc Candidates - Apply Online. CSIR-CFTRI Job Opening. MSc Biotechnology/...
Govt of India HLL Lifecare Limited Biotech, Biochem & Microbiology Jobs
HLL Job Openings 2022 For Biotech, Biochem & Microbiology
HLL Lifecare Limited (HLL) is a Govt. of India Healthcare products manufacturing and services Company based...
PI Industries Research Scientist – Molecular Biology Recruitment, Apply Online
PI Industries Research Scientist - Molecular Biology Recruitment, Apply Online
PI Industries Research Scientist - Molecular Biology Recruitment, Apply Online. Ph.D/M. Tech/M.S/B.Tech Mol Bio &...
Govt of Gujarat GBU JRF Job For MSc Biotech, Biochem, Life Sciences & Microbiology
GBU Project JRF Job For MSc Biotech, Biochem, Applications Invited
GBU Project JRF Job For MSc Biotech, Biochem, Applications Invited. Gujarat Biotechnology University Jobs. Junior...
MSSRF MSc Microbiology & Agriculture JRF Job Opening, Applications Invited
MSSRF MSc Microbiology & Agriculture JRF Job Opening, Applications Invited
About MSSRF: The M. S. Swaminathan Research Foundation (MSSRF) was established in 1988 as a...
Pepsico India MSc & BTech Food Tech, Microbiology SC Job Opening
Pepsico QC Job Opening, MSc & BTech Apply Online
Pepsico QC Job Opening, MSc & BTech Apply Online. Interested and eligible candidates can check the...
CSIR-IITR Life, Biological Sciences, Microbiology, Biotech, Bioinformatics Jobs
IITR Jobs For MSc Biotech, Microbiology, Biological & Life Sciences
IITR Jobs For MSc Biotech, Microbiology, Biological & Life Sciences. Indian Institute of Toxicology Research...
Top 10 Most Important Topics To Study From Developmental Biology – CSIR NET Life...
CSIR NET Unit 5 Important Topics - CSIR NET Developmental Biology Important Topic List
The CSIR NET is an extensive and challenging examination conducted twice...